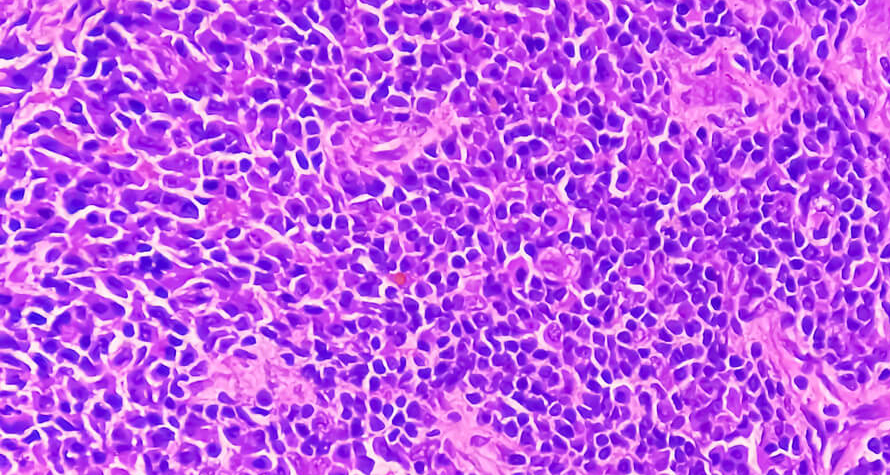
...

Digital Pathologists
Networking Platform
For
IKET is a Digital Pathologists Networking Platform where "knowledge" and "experience" are standardized for a sustainable report quality approach for all cases with a certain standardization and know-how.
DiscoverWhich Pathologists need IKET ?

PRIVATE LABORATORIES
Any Laboratories which is looking for new digital pathologist in his laboratory
Any Laboratories which are looking for a solution to lower their high labor cost of acquiring full-time experienced digiral pathologist on-site
Any Laboratories which are stuck with limited working hours of their on-site pathologist and want to adjust the work balance in their institution with online pathologists

HOSPITALS
Any Hospitals who are facing lack of enough pathologists for their usual or special cases
Any Hospitals who wants expetied the long diagnosis time of their difficult cases
Any Hospitals in remote location area, who must solve their lack of enough on-site pathologist by remote experienced online pathologists

ONLINE DIGITAL PATHOLOGISTS
Any online digital pathologist, who are looking for new opportunities
International pathologists who want to work worldwide online remotely
Any online digital pathologist, who wants to have an easy request making capability if they were in the laboratory
What are the solutions by IKET

Problem:
Lack of pathologist worldwide
Solution:
Access quickly to remote Digital Pathologist
IKET can provide you the digital pathology experienced pathologist you need, quickly through its remote Digital Pathologist Network.

Problem:
High labor cost of acquiring full-time digital pathologists onsite.
Solution:
Charged by completed diagnosis only
At IKET’s Remote Digital Pathologist Networking Platform, pathologists can access your cases remotely and you will be charged by completed diagnosis only. You use IKET Digital Pathologist Networking Platform as much as you need only and you will obtain a cost advantage in your consolidation labor expenses

Problem:
Limited working hours
Solution:
Able to view slides 24/7 digitally from a remote location
At IKET Digital Pathologist Networking Platform, worldwide pathologists are able to view your slides 24/7 digitally from a remote location any time when there is need for diagnosis

Problem:
Lack of on-site experienced pathologists in remote locations
Solution:
Able to solve your on-site pathologist need remotely
If your institution is in remote area, you can easily find an experienced digital pathologist through IKET Digital Pathologist Networking Platform and solve your on-site pathologist need remotely.

Problem:
Pathologists who are unfamiliar with whole slide imaging technology
Solution:
Easily find "whole slide imaging technology" experineced remote digital pathologist
IKET Digital Pathologist Networking Platform, will give a great opportunity to work with digital pathology experienced pathologist who has knowledge on whole slide imaging technology worldwide remotely

Problem:
Language barriers in communication for the need of international consultation on cases
Solution:
Pathologists ready with fluent medical English writing and speaking
At IKET Digital Pathologist Networking Platform, all pathologies are fluent at medical English both in writing and speaking

Problem:
Remote access for Digital Pathology requires a certain computer hardware.
Solution:
Well equipped digital pathologists
At IKET Digital Pathologist Networking Platform, all digital pathologists are well equipped in order to communicate remotely in IKET’s standardized structure.

Problem:
Need of making "extra requesting" in complex cases
Solution:
Able to make "extra requesting"
With the IKET Pathologist Network System, pathologists can make requests in complex cases as if they were in the laboratory. IKET Digital Pathologist Networking Platform will also give you an opportunity to work with different specialized foreign pathologists internationally in difficult cases that require "special diagnosis" and will save you time on diagnosis of difficult cases

Problem:
Difficulties in workload balancing of your on-site digital pathologists
Solution:
Easily find an experienced digital pathologist
With IKET Remote Digital Pathologist Networking Platform, you can easily find an experienced digital pathologist and balance your workload without any time loss on your cases.